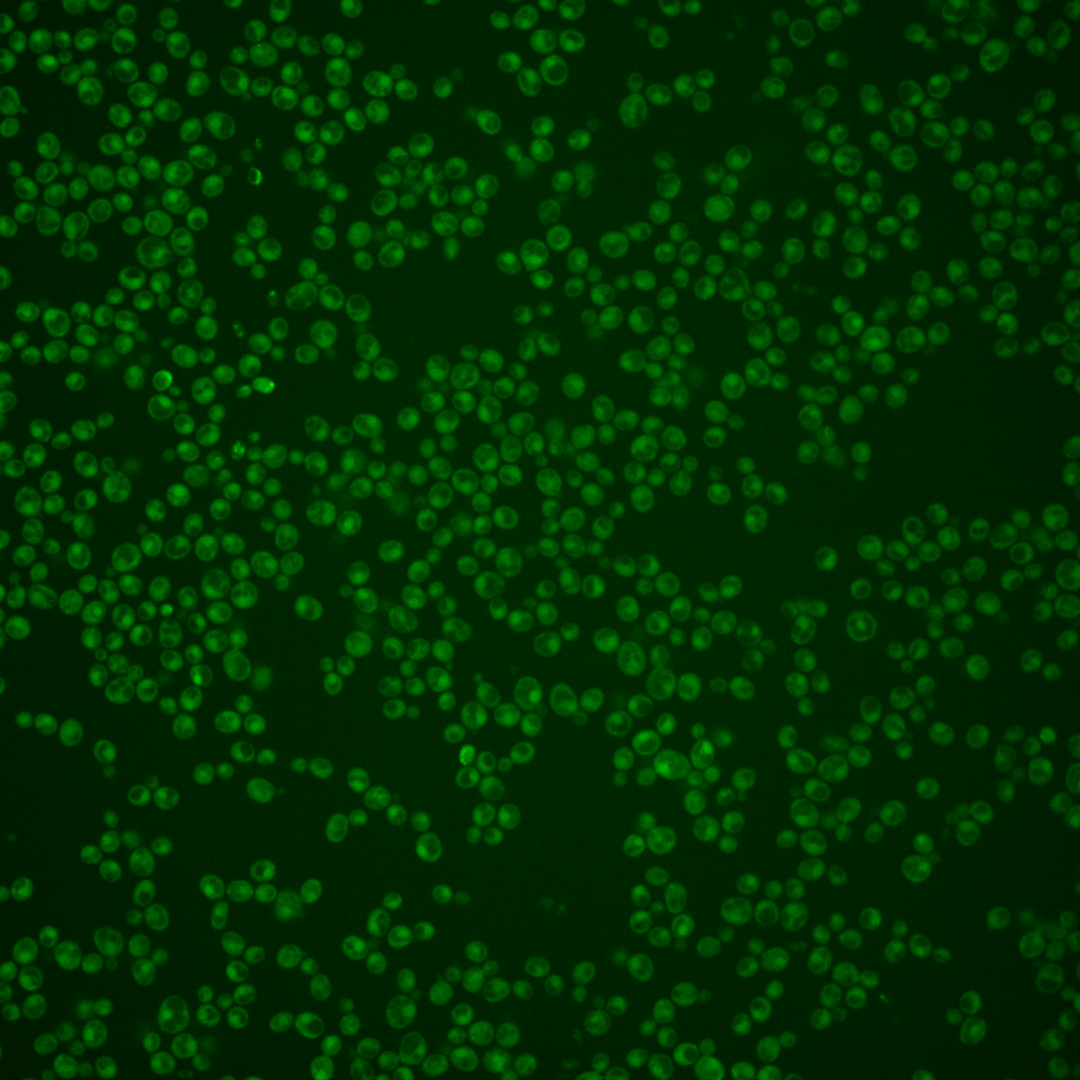
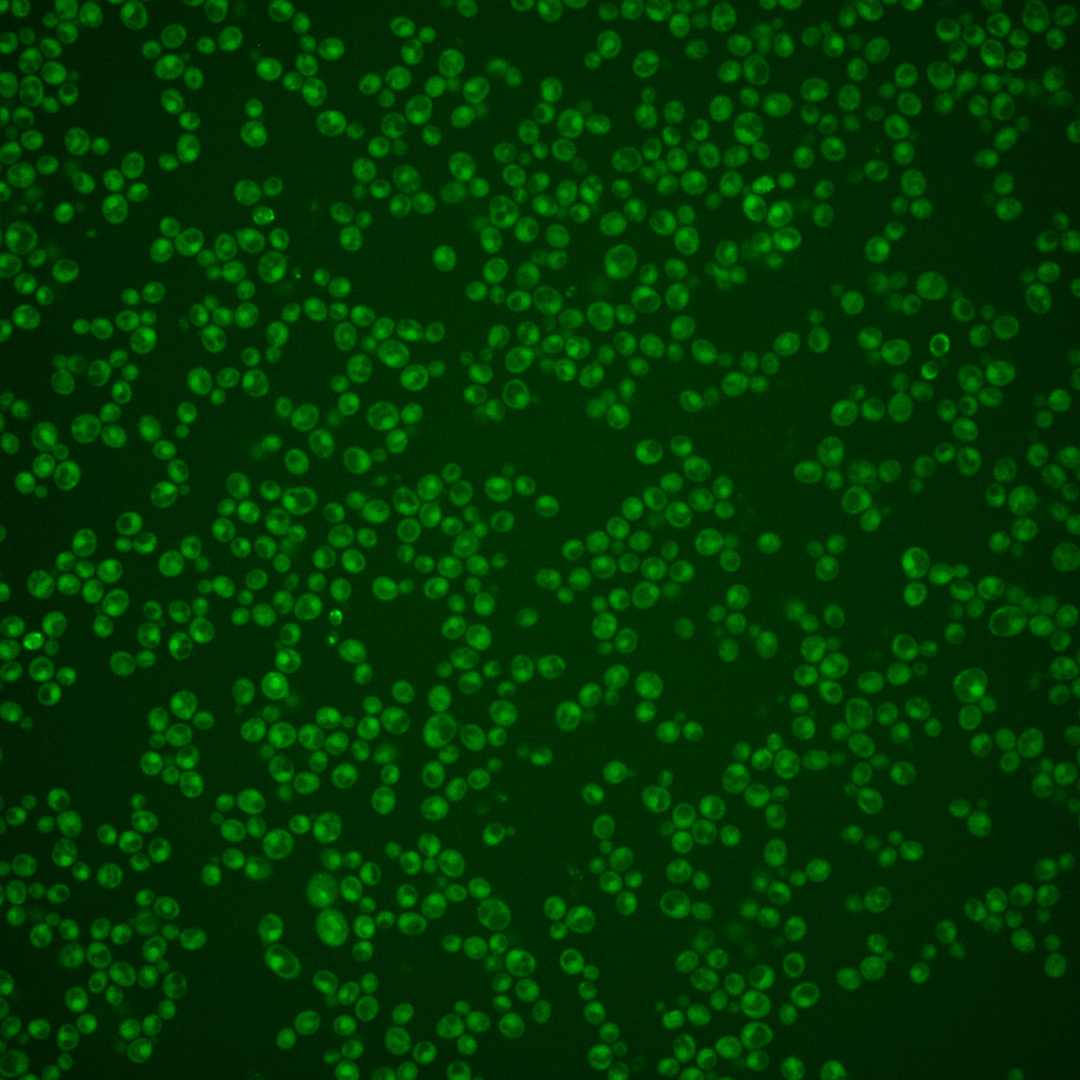
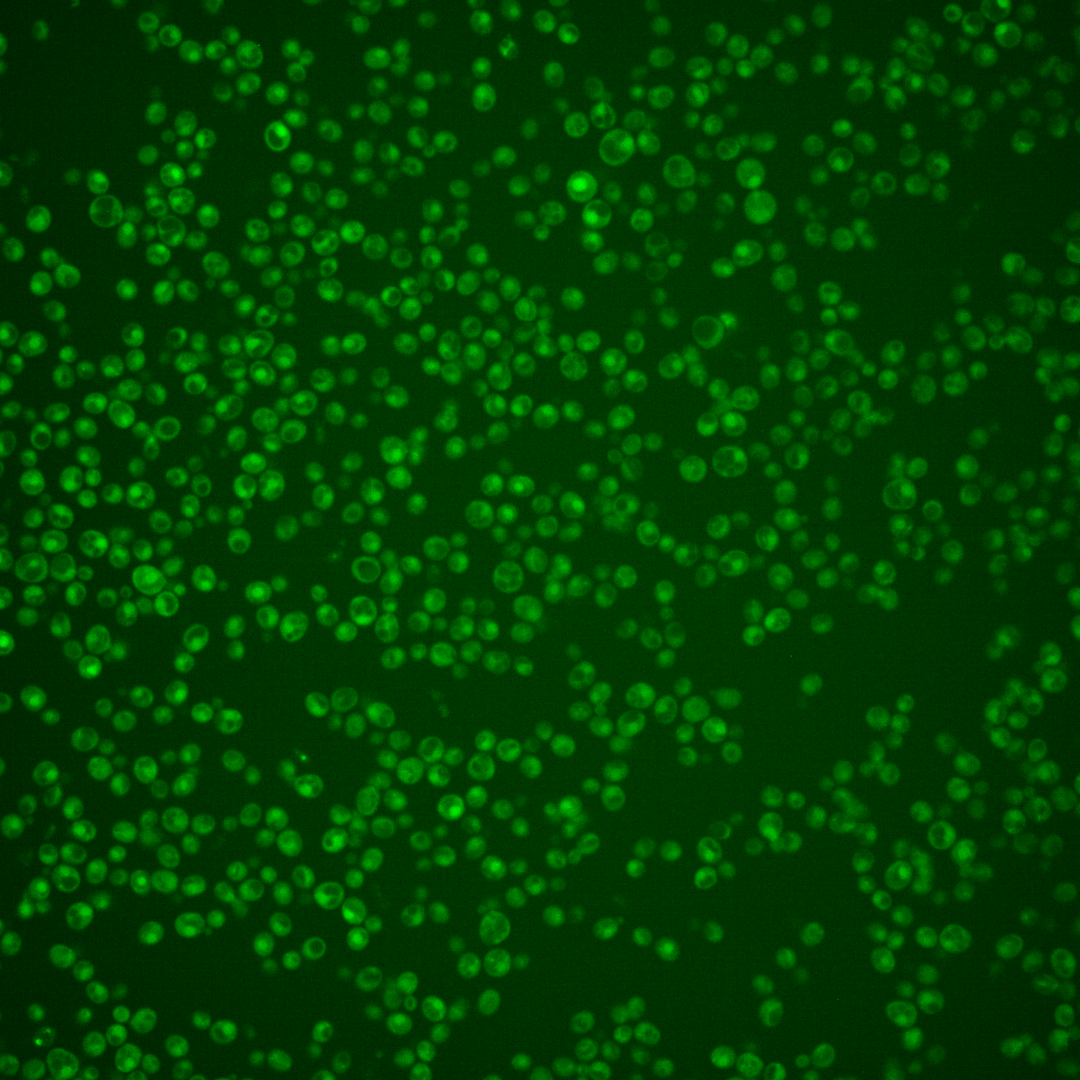
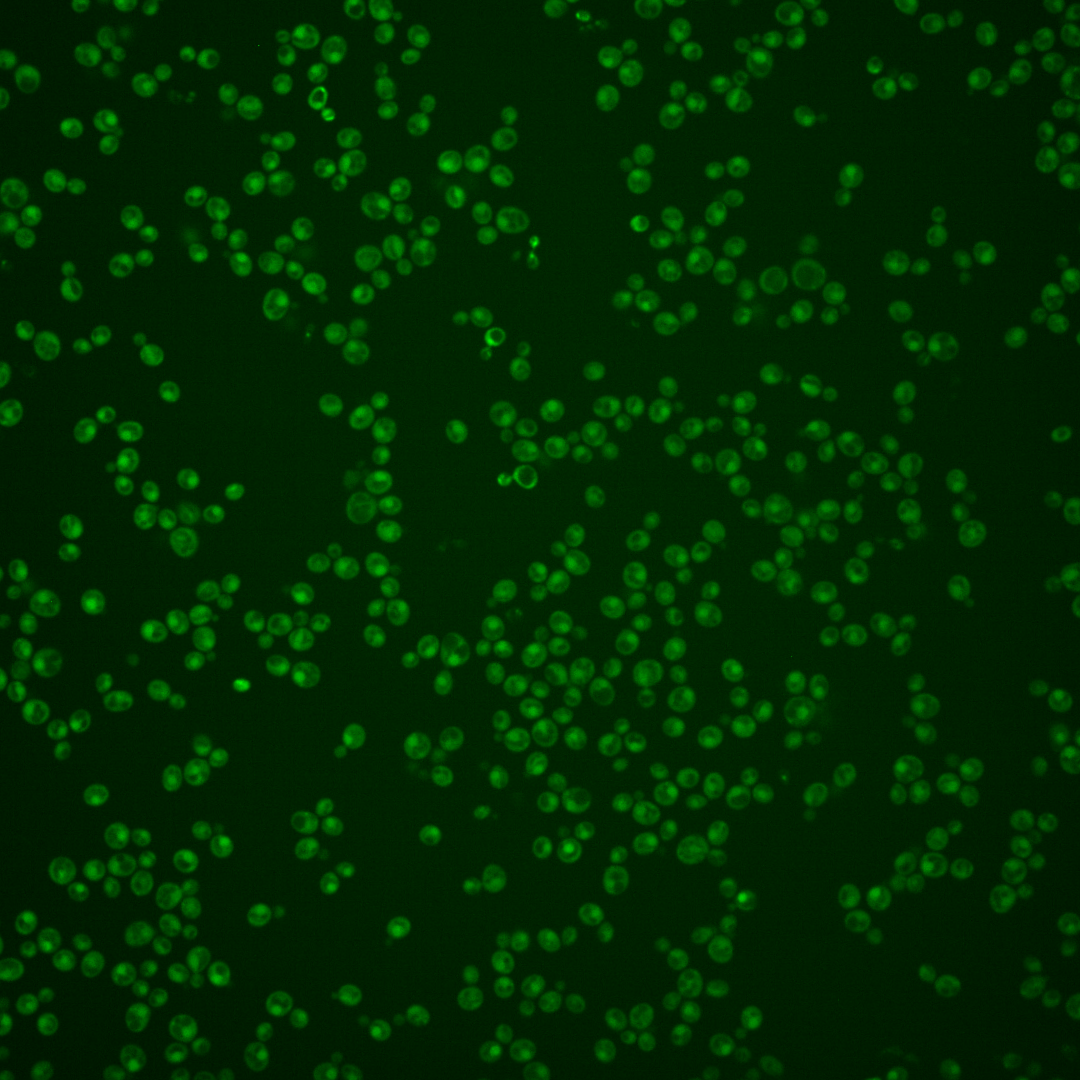
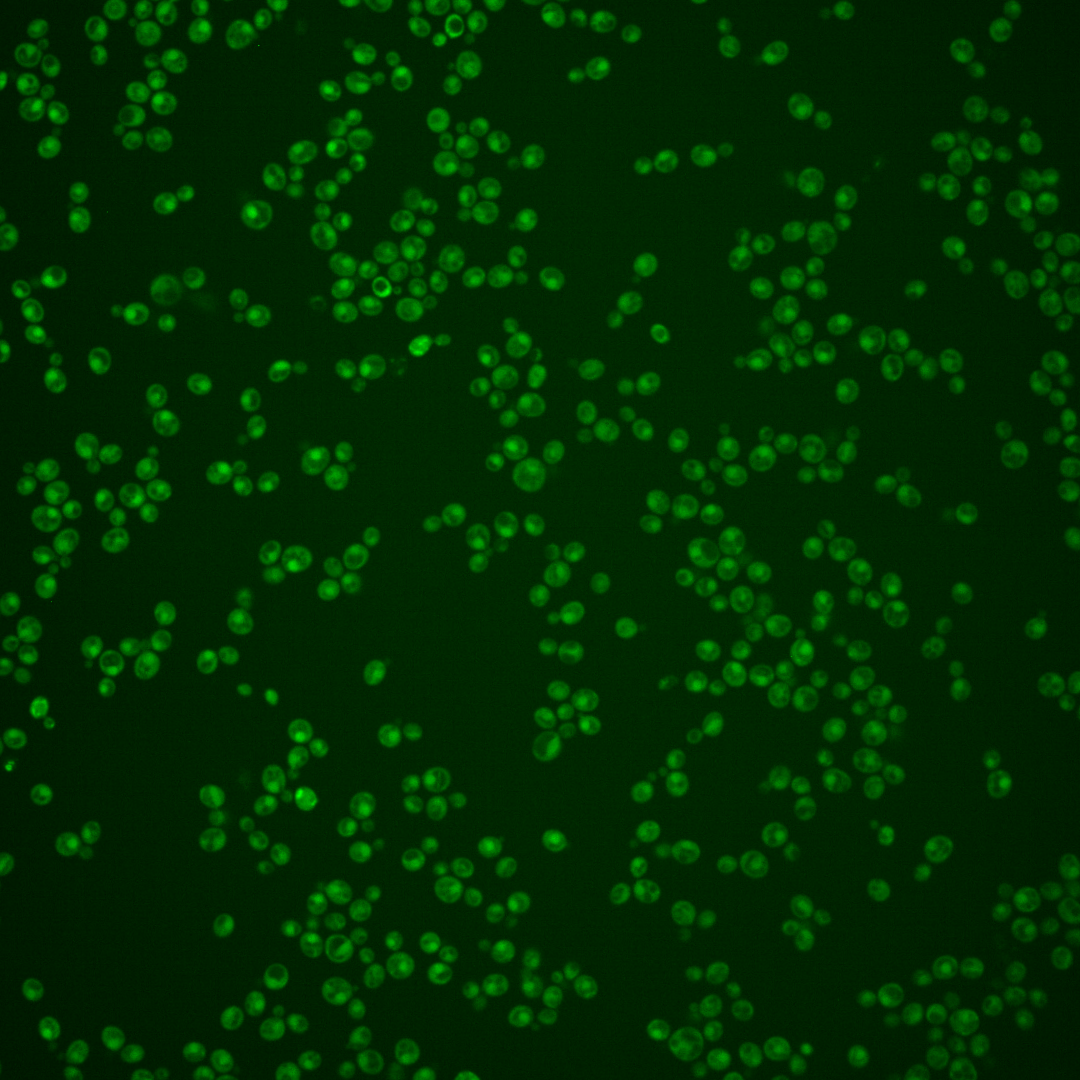
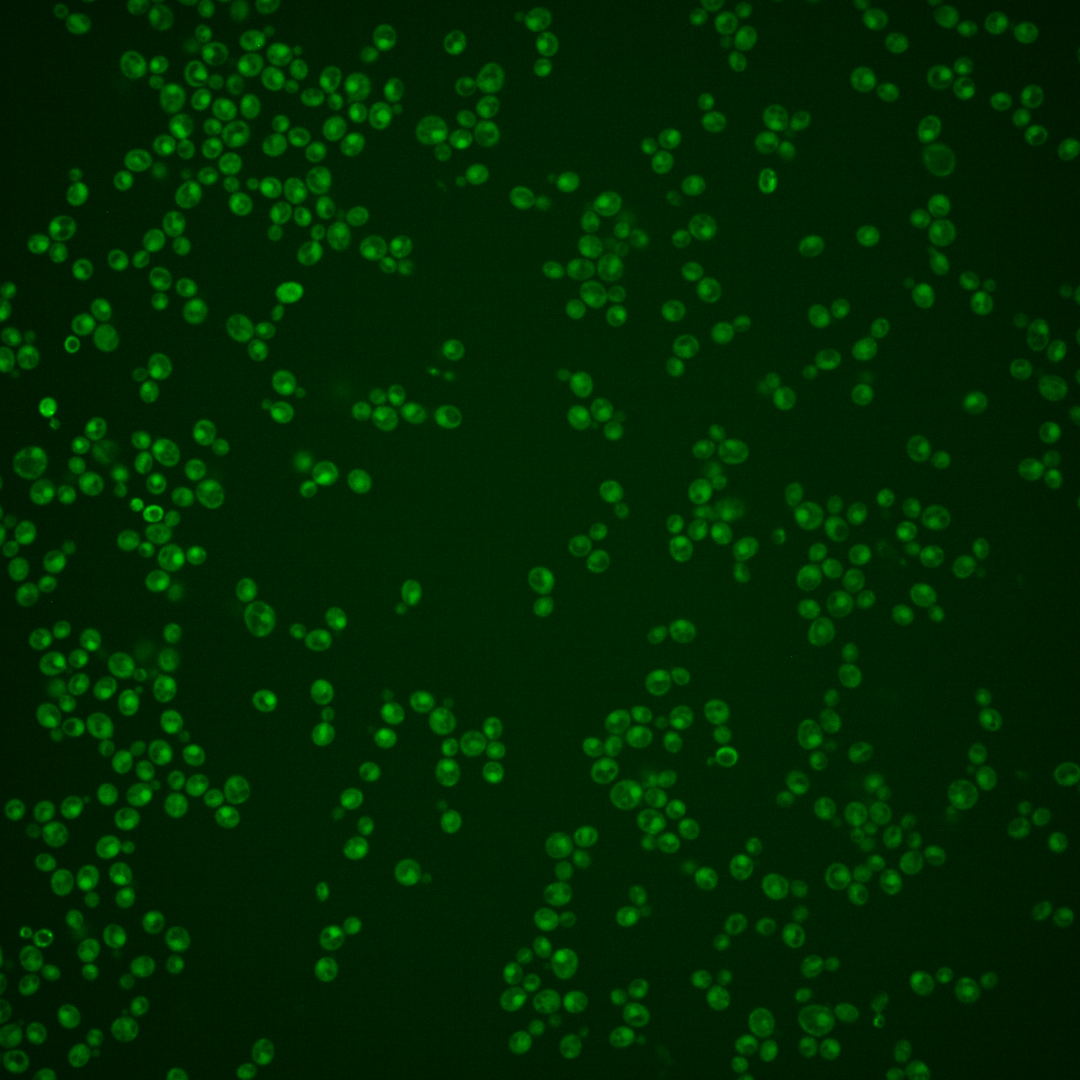

| Standard name | |
|---|---|
| Human Ortholog | |
| Description | Probable DNA helicase; involved in sister-chromatid cohesion and genome integrity and interstrand cross-link repair; interacts with ECO1 and CTF18; mutants are defective in silencing, rDNA recombination, aging and the heat shock response; FANCJ-like helicase family member; mutations in the human homolog, DDX11/ChLR1, cause Warsaw breakage syndrome |
Micrographs




















































































Sub-cellular Localization
Yeast GFP Assignment
Protein Abundance
Localization Change
External localization resources
| ensLOC | DeepLoc | |||||||||||||||||||||||
|---|---|---|---|---|---|---|---|---|---|---|---|---|---|---|---|---|---|---|---|---|---|---|---|---|
| Localization | WT1 | WT2 | WT3 | RAP60 | RAP140 | RAP220 | RAP300 | RAP380 | RAP460 | RAP540 | RAP620 | RAP700 | HU80 | HU120 | HU160 | rpd3Δ_1 | rpd3Δ_2 | rpd3Δ_3 | WT1 | WT2 | WT3 | AF100 | AF140 | AF180 |
| Cortical Patches | 0 | 1 | 0 | 0 | 0 | 0 | 0 | 2 | 0 | 0 | 0 | 1 | 0 | 0 | 0 | 0 | 0 | 0 | 0 | 1 | 0 | 3 | 6 | 8 |
| Bud | 0 | 1 | 0 | 0 | 0 | 1 | 2 | 5 | 4 | 2 | 11 | 3 | 0 | 0 | 1 | 1 | 0 | 0 | 4 | 1 | 4 | 0 | 15 | 8 |
| Bud Neck | 0 | 2 | 6 | 7 | 11 | 4 | 3 | 23 | 7 | 3 | 2 | 7 | 0 | 0 | 0 | 1 | 0 | 0 | 0 | 1 | 1 | 1 | 4 | 6 |
| Bud Site | 0 | 0 | 0 | 0 | 0 | 1 | 2 | 0 | 5 | 3 | 8 | 10 | 0 | 0 | 0 | 0 | 0 | 0 | – | – | – | – | – | – |
| Cell Periphery | 0 | 0 | 1 | 1 | 1 | 0 | 0 | 1 | 1 | 0 | 1 | 0 | 0 | 0 | 0 | 0 | 0 | 1 | 0 | 0 | 0 | 0 | 1 | 0 |
| Cytoplasm | 88 | 80 | 204 | 189 | 215 | 180 | 251 | 249 | 198 | 180 | 106 | 131 | 120 | 160 | 254 | 126 | 104 | 111 | 57 | 82 | 132 | 65 | 108 | 127 |
| Endoplasmic Reticulum | 4 | 6 | 0 | 0 | 1 | 0 | 0 | 1 | 0 | 0 | 0 | 0 | 0 | 0 | 0 | 16 | 11 | 13 | 1 | 0 | 1 | 1 | 3 | 8 |
| Endosome | 1 | 0 | 0 | 1 | 0 | 0 | 0 | 1 | 1 | 0 | 0 | 0 | 2 | 11 | 7 | 9 | 4 | 14 | 6 | 0 | 1 | 2 | 5 | 7 |
| Golgi | 0 | 0 | 0 | 0 | 0 | 0 | 0 | 0 | 0 | 0 | 0 | 0 | 0 | 0 | 0 | 1 | 0 | 2 | 1 | 0 | 0 | 0 | 4 | 1 |
| Mitochondria | 39 | 42 | 9 | 31 | 10 | 74 | 134 | 102 | 210 | 172 | 200 | 150 | 29 | 13 | 12 | 6 | 5 | 5 | 11 | 16 | 17 | 19 | 52 | 39 |
| Nucleus | 29 | 14 | 5 | 14 | 27 | 19 | 53 | 69 | 50 | 51 | 46 | 50 | 29 | 18 | 10 | 24 | 52 | 36 | 87 | 33 | 30 | 24 | 28 | 13 |
| Nuclear Periphery | 2 | 0 | 0 | 0 | 0 | 0 | 0 | 0 | 1 | 0 | 2 | 0 | 0 | 0 | 1 | 0 | 1 | 0 | 1 | 0 | 1 | 0 | 0 | 0 |
| Nucleolus | 1 | 0 | 0 | 1 | 0 | 0 | 0 | 0 | 0 | 1 | 0 | 0 | 0 | 0 | 0 | 0 | 0 | 0 | 0 | 0 | 0 | 0 | 0 | 0 |
| Peroxisomes | 0 | 0 | 0 | 0 | 0 | 0 | 0 | 0 | 0 | 0 | 0 | 0 | 0 | 0 | 0 | 0 | 1 | 1 | 0 | 0 | 0 | 0 | 0 | 0 |
| SpindlePole | 0 | 0 | 1 | 4 | 3 | 2 | 11 | 8 | 4 | 2 | 6 | 7 | 0 | 0 | 0 | 2 | 0 | 0 | 7 | 5 | 8 | 3 | 9 | 7 |
| Vac/Vac Membrane | 73 | 16 | 26 | 11 | 33 | 15 | 13 | 30 | 18 | 20 | 9 | 21 | 71 | 130 | 128 | 91 | 68 | 108 | 74 | 59 | 102 | 81 | 158 | 118 |
| Unique Cell Count | 203 | 145 | 240 | 243 | 278 | 258 | 397 | 419 | 390 | 362 | 304 | 299 | 228 | 291 | 363 | 234 | 219 | 246 | 261 | 213 | 316 | 214 | 413 | 363 |
| Labelled Cell Count | 237 | 162 | 252 | 259 | 301 | 296 | 469 | 491 | 499 | 434 | 391 | 380 | 251 | 332 | 413 | 277 | 246 | 291 | 261 | 213 | 316 | 214 | 413 | 363 |
Yeast GFP Assignment
Protein Abundance
| Screen | WT1 | WT2 | WT3 | RAP60 | RAP140 | RAP220 | RAP300 | RAP380 | RAP460 | RAP540 | RAP620 | RAP700 | HU80 | HU120 | HU160 | rpd3Δ_1 | rpd3Δ_2 | rpd3Δ_3 | AF100 | AF140 | AF180 |
|---|---|---|---|---|---|---|---|---|---|---|---|---|---|---|---|---|---|---|---|---|---|
| Mean Cell GFP Intensity (1e-4) | 3.9 | 3.3 | 4.7 | 4.2 | 4.9 | 3.7 | 3.9 | 4.0 | 3.5 | 3.4 | 3.0 | 3.6 | 4.1 | 4.1 | 4.3 | 6.0 | 6.0 | 5.8 | 3.9 | 4.2 | 4.4 |
| Std Deviation (1e-4) | 1.0 | 0.5 | 1.2 | 1.3 | 1.5 | 1.4 | 1.1 | 1.2 | 2.0 | 1.3 | 0.7 | 0.6 | 1.3 | 1.0 | 1.3 | 1.8 | 1.3 | 1.2 | 1.2 | 2.2 | 1.8 |
| Intensity Change (Log2) | – | – | – | -0.15 | 0.07 | -0.34 | -0.27 | -0.21 | -0.44 | -0.47 | -0.66 | -0.38 | -0.18 | -0.19 | -0.12 | 0.36 | 0.35 | 0.3 | -0.26 | -0.17 | -0.09 |
Localization Change
| Localization | RAP60 | RAP140 | RAP220 | RAP300 | RAP380 | RAP460 | RAP540 | RAP620 | RAP700 | HU80 | HU120 | HU160 | rpd3Δ_1 | rpd3Δ_2 | rpd3Δ_3 |
|---|---|---|---|---|---|---|---|---|---|---|---|---|---|---|---|
| Actin | – | – | – | – | – | – | – | – | – | – | – | – | – | – | – |
| Bud | – | – | – | – | – | – | – | – | – | – | – | – | 0 | 0 | 0 |
| Bud Neck | – | – | – | – | – | – | – | – | – | – | – | – | 0 | 0 | 0 |
| Bud Site | – | – | – | – | – | – | – | – | – | – | – | – | 0 | 0 | 0 |
| Cell Periphery | – | – | – | – | – | – | – | – | – | – | – | – | 0 | 0 | 0 |
| Cyto | – | – | – | – | – | – | – | – | – | – | – | – | – | – | – |
| Endoplasmic Reticulum | – | – | – | – | – | – | – | – | – | – | – | – | 0 | 0 | 0 |
| Endosome | – | – | – | – | – | – | – | – | – | – | – | – | 0 | 0 | 0 |
| Golgi | – | – | – | – | – | – | – | – | – | – | – | – | 0 | 0 | 0 |
| Mitochondria | – | – | – | – | – | – | – | – | – | – | – | – | 0 | 0 | 0 |
| Nuclear Periphery | – | – | – | – | – | – | – | – | – | – | – | – | 0 | 0 | 0 |
| Nuc | – | – | – | – | – | – | – | – | – | – | – | – | – | – | – |
| Nucleolus | – | – | – | – | – | – | – | – | – | – | – | – | 0 | 0 | 0 |
| Peroxisomes | – | – | – | – | – | – | – | – | – | – | – | – | 0 | 0 | 0 |
| SpindlePole | – | – | – | – | – | – | – | – | – | – | – | – | 0 | 0 | 0 |
| Vac | – | – | – | – | – | – | – | – | – | – | – | – | – | – | – |
| Cortical Patches | – | – | – | – | – | – | – | – | – | – | – | – | 0 | 0 | 0 |
| Cytoplasm | – | – | – | – | – | – | – | – | – | – | – | – | 0 | 0 | 0 |
| Nucleus | – | – | – | – | – | – | – | – | – | – | – | – | 0 | 0 | 0 |
| Vacuole | – | – | – | – | – | – | – | – | – | – | – | – | 7.1 | 5.4 | 8.2 |
External localization resources
Images






























Protein Concentration and Protein Localization Data
| R1 | R2 | R3 | ||||||||||||||||
|---|---|---|---|---|---|---|---|---|---|---|---|---|---|---|---|---|---|---|
| G1 Pre-START | G1 Post-START | S/G2 | Metaphase | Anaphase | Telophase | G1 Pre-START | G1 Post-START | S/G2 | Metaphase | Anaphase | Telophase | G1 Pre-START | G1 Post-START | S/G2 | Metaphase | Anaphase | Telophase | |
| Concentration | 1.6048 | 1.8065 | 2.1197 | 0.6866 | 1.0019 | 1.7788 | -0.94 | -0.7744 | -0.8169 | -0.775 | -0.9968 | -0.8968 | 0.315 | -0.696 | -0.7216 | -0.2905 | -1.2024 | -0.9106 |
| Actin | 0.0313 | 0.0147 | 0.0107 | 0.0008 | 0.0146 | 0.0014 | 0.0302 | 0.0002 | 0.0024 | 0.0106 | 0.0036 | 0.0021 | 0.0498 | 0.0032 | 0.0124 | 0.0682 | 0.0001 | 0.0278 |
| Bud | 0.0002 | 0.0001 | 0.0008 | 0.0001 | 0.0003 | 0.0001 | 0.0018 | 0.0045 | 0.0001 | 0.0002 | 0.0022 | 0.0005 | 0.0021 | 0.0017 | 0.0014 | 0.0004 | 0.0001 | 0.0003 |
| Bud Neck | 0.0138 | 0.0004 | 0.0013 | 0.0011 | 0.001 | 0.0042 | 0.0027 | 0.0003 | 0.0011 | 0.0006 | 0.0016 | 0.0087 | 0.0132 | 0.0004 | 0.0029 | 0.0015 | 0.001 | 0.0023 |
| Bud Periphery | 0.0004 | 0.0001 | 0.0024 | 0.0002 | 0.0007 | 0.0002 | 0.0015 | 0.0005 | 0.0001 | 0.0002 | 0.0033 | 0.0013 | 0.0032 | 0.0035 | 0.0014 | 0.0005 | 0.0001 | 0.0004 |
| Bud Site | 0.0053 | 0.0017 | 0.0054 | 0.0002 | 0.0034 | 0.0002 | 0.0085 | 0.0014 | 0.0015 | 0.0004 | 0.0044 | 0.0007 | 0.0138 | 0.0088 | 0.0063 | 0.0011 | 0.0002 | 0.0003 |
| Cell Periphery | 0.0002 | 0.0004 | 0.0033 | 0.0001 | 0.0004 | 0.0003 | 0.0005 | 0.0001 | 0.0001 | 0.0001 | 0.0001 | 0.0001 | 0.0009 | 0.0003 | 0.0003 | 0.0001 | 0 | 0.0001 |
| Cytoplasm | 0.1684 | 0.1607 | 0.1196 | 0.2282 | 0.2293 | 0.2198 | 0.1912 | 0.2656 | 0.1859 | 0.1594 | 0.2304 | 0.2306 | 0.1994 | 0.2764 | 0.2724 | 0.1362 | 0.2628 | 0.2667 |
| Cytoplasmic Foci | 0.0118 | 0.0057 | 0.0261 | 0.003 | 0.0113 | 0.0118 | 0.032 | 0.005 | 0.0126 | 0.01 | 0.0149 | 0.0168 | 0.0495 | 0.0067 | 0.0107 | 0.021 | 0.0049 | 0.0247 |
| Eisosomes | 0.0009 | 0.0002 | 0.0007 | 0.0001 | 0.0016 | 0.0002 | 0.0004 | 0.0001 | 0.0001 | 0.0001 | 0.0001 | 0 | 0.0007 | 0.0002 | 0.0002 | 0.0002 | 0 | 0.0001 |
| Endoplasmic Reticulum | 0.0051 | 0.0062 | 0.005 | 0.0037 | 0.0033 | 0.0032 | 0.0055 | 0.0041 | 0.0044 | 0.0022 | 0.0034 | 0.0027 | 0.0125 | 0.0098 | 0.0062 | 0.0126 | 0.0022 | 0.0074 |
| Endosome | 0.006 | 0.0021 | 0.0044 | 0.0028 | 0.0241 | 0.0043 | 0.0351 | 0.0038 | 0.0148 | 0.0273 | 0.0231 | 0.0072 | 0.05 | 0.0053 | 0.0185 | 0.028 | 0.0022 | 0.0126 |
| Golgi | 0.0027 | 0.0002 | 0.0026 | 0.0001 | 0.0118 | 0.0006 | 0.0059 | 0.0001 | 0.0014 | 0.0148 | 0.0139 | 0.0026 | 0.0197 | 0.0004 | 0.005 | 0.0172 | 0 | 0.0048 |
| Lipid Particles | 0.0136 | 0.0025 | 0.011 | 0.0009 | 0.0493 | 0.0086 | 0.0166 | 0.0005 | 0.006 | 0.0093 | 0.0051 | 0.0044 | 0.0341 | 0.0013 | 0.0025 | 0.0105 | 0.0005 | 0.0051 |
| Mitochondria | 0.0067 | 0.0005 | 0.0185 | 0.0019 | 0.0633 | 0.0012 | 0.0174 | 0.0007 | 0.002 | 0.0053 | 0.0062 | 0.002 | 0.0185 | 0.0046 | 0.0058 | 0.0046 | 0.0003 | 0.0025 |
| None | 0.5481 | 0.6278 | 0.628 | 0.5651 | 0.3404 | 0.4846 | 0.3325 | 0.4695 | 0.3904 | 0.3768 | 0.3768 | 0.2463 | 0.3669 | 0.4489 | 0.3811 | 0.3761 | 0.3879 | 0.2744 |
| Nuclear Periphery | 0.0153 | 0.0063 | 0.0186 | 0.0198 | 0.0046 | 0.0056 | 0.0153 | 0.0142 | 0.0277 | 0.0118 | 0.0173 | 0.0089 | 0.023 | 0.0254 | 0.0191 | 0.0289 | 0.0064 | 0.0184 |
| Nucleolus | 0.0015 | 0.0013 | 0.0022 | 0.0022 | 0.0015 | 0.003 | 0.0049 | 0.0021 | 0.0086 | 0.0034 | 0.004 | 0.0049 | 0.0022 | 0.002 | 0.0023 | 0.0012 | 0.0017 | 0.0056 |
| Nucleus | 0.1441 | 0.1627 | 0.1097 | 0.1536 | 0.1852 | 0.2174 | 0.2157 | 0.2134 | 0.3036 | 0.3388 | 0.2468 | 0.3934 | 0.0872 | 0.1769 | 0.2147 | 0.2745 | 0.3038 | 0.281 |
| Peroxisomes | 0.0165 | 0.0008 | 0.021 | 0.0004 | 0.0428 | 0.0063 | 0.0309 | 0.0001 | 0.0042 | 0.0044 | 0.0039 | 0.015 | 0.0216 | 0.0008 | 0.0012 | 0.0031 | 0.0001 | 0.0011 |
| Punctate Nuclear | 0.0062 | 0.0037 | 0.0054 | 0.0125 | 0.0055 | 0.025 | 0.039 | 0.0112 | 0.029 | 0.0193 | 0.0328 | 0.0498 | 0.0195 | 0.0158 | 0.0295 | 0.011 | 0.0244 | 0.0612 |
| Vacuole | 0.0016 | 0.0017 | 0.0024 | 0.0021 | 0.004 | 0.0018 | 0.0084 | 0.0021 | 0.0032 | 0.0034 | 0.0047 | 0.0017 | 0.0095 | 0.0065 | 0.0042 | 0.0018 | 0.001 | 0.0021 |
| Vacuole Periphery | 0.0006 | 0.0002 | 0.0008 | 0.0008 | 0.0015 | 0.0003 | 0.0039 | 0.0004 | 0.0009 | 0.0016 | 0.0014 | 0.0004 | 0.0027 | 0.0015 | 0.0018 | 0.0013 | 0.0002 | 0.0009 |
Sequencing Data
| R1 | R2 | |||||||||
|---|---|---|---|---|---|---|---|---|---|---|
| G1 Post-START | S/G2 | Metaphase | Anaphase | Telophase | G1 Post-START | S/G2 | Metaphase | Anaphase | Telophase | |
| Gene Expression | 13.2272 | 8.7729 | 7.359 | 11.136 | 12.1707 | 8.529 | 8.581 | 8.0692 | 9.9187 | 12.9302 |
| Translational Efficiency | 0.3489 | 0.3726 | 0.4224 | 0.3628 | 0.2657 | 0.5911 | 0.4796 | 0.3802 | 0.2438 | 0.3064 |
Hit Data
| Dataset | Hit |
|---|---|
| Protein Concentration | ✘ |
| Protein Localization | ✘ |
| Gene Expression | ✔ |
| Translational Efficiency | ✘ |
Endocytosis
| Temp | Actin Patch (Sac6-tdTomato) | Cortical Patch (Sla1-GFP) | Late Endosome (Snf7-GFP) | Vacuole (Vph1-GFP) |
|---|---|---|---|---|
| 37℃ | ||||
| RT |
Cell Cycle Omics
CYCLoPs (Chl1-GFP)
| Gene / Allele | Actin Patch (Sac6-tdTomato) | Cortical Patch (Sla1-GFP) | Late Endosome (Snf7-GFP) | Vacuole (Sac6-tdTomato) |
|---|
| Gene | Images |
|---|
| Gene | Images |
|---|
Images are not yet available
Images are not yet available